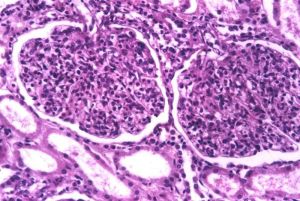
急性瀰漫性增生性腎小球腎炎

病理變化
急性瀰漫性增生性腎小球腎炎2)鏡下:病變為瀰漫性,雙側腎小球廣泛受累,腎小球體積增大,細胞數量增多,內皮細胞和系膜細胞的增生及嗜中性粒細胞、單核細胞浸潤。有時伴有髒層上皮細胞的增生,病變發展可堵塞毛細血管,毛細血管通透性增加,血漿蛋白質得以濾過進入腎球囊,因此,病人尿中常有蛋白質和白細胞。輕型病人,病變不再發展,以後逐漸痊癒,比較嚴重的病人,病變繼續發展,腎小球內細胞增生加重,增生的細胞主要是系膜細胞和內皮細胞。增生細胞壓迫毛細血管,使管腔狹窄甚至閉塞。病變嚴重時節段性纖維素樣壞死,並破裂出血,大量紅細胞進入腎球囊及腎小管腔內,可以引起明顯的血尿。不同的病例病變表現形式可能不同,有的以滲出為主,稱為急性滲出性腎小球腎炎,有些病變嚴重,腎小球毛細血管壞死,有大量出血者稱為出血性腎小球性腎炎。上皮細胞一般無明顯增生,少數嚴重的病例腎小球的壁層和髒層上皮細胞可增生,形成新月體。這種病變容易引起腎小球纖維化。如數量少,對功能影響不大。如病變廣泛,可形成新月體。
腎小球的病變常可引起相應的腎小管缺血,腎小管上皮細胞常有濁腫、玻璃樣變、脂肪變等。管腔內含有從腎小球濾過的蛋白、紅細胞、白細胞、脫落的上皮細胞,這些物質在腎小管內凝集,形成各種管型,如蛋白管型、透明管型、細胞管型(如紅細胞、白細胞或上皮細胞管型)和顆粒管型。
腎間質內常有不同程度的充血、水腫和少量淋巴細胞和中性粒細胞浸潤。
3)電鏡下腎小球系膜細胞和內皮細胞增生腫脹,有散在的電子密度高的沉積物在髒層上皮細胞和腎小球基底膜之間,呈駝峰狀,沉積物也可位於內皮細胞下或基底膜內。沉積物表面的上皮細胞足突融合消失,沉積物一般在發病幾天后就可出現,在4-6周內消失,有時基底膜內側內皮細胞下和系膜內也可見小型沉積物。
免疫螢光顯示沿腎小球基底膜和系膜區有散在的IgG和補體C3的沉積,呈顆粒狀螢光。
臨床病理聯繫
腎常表現為急性腎炎綜合徵。如蛋白尿,血尿,管型尿,水腫和高血壓,可出現少尿,嚴重者可出現氮質血症。預後與年齡有關,兒童患者大都能恢復。成人預後差。少數病人可轉為隱匿性腎炎或新月體性腎炎。
飲食方法
補益配方1
組成:大蒜適量鯽魚1條
用法:鯽魚去鱗及內臟,洗淨,大蒜切碎入魚肚內,用荷葉包裹,放在燃燒的谷糠中煨熟食用。
功效:本方溫補利水,適用於慢性腎炎
補益配方2
組成:炙黃芪24g山藥50g山庾肉10g
用法:水煎服,每日1劑。
功效:本方適用於氣虛所致慢性腎炎。
補益配方3
組成:鮮牛奶500-1000ml
用法:煮沸,每日早晚兩次使用。
功效:本方適用於腎病體虛,蛋白流失過多者。
補益配方4
組成:紅棗100g花生米100g
用法:將上品共入鍋內,加水適量,文火煎湯,食棗、花生米,飲湯。
功效:本方適用於慢性腎炎氣虛明顯者。
補益配方5
組成:黃芪50g鯉魚湯500g生薑10g
用法:將鯉魚去鱗和內臟洗淨,黃芪、生薑洗淨,用紗布包好。將鯉魚、黃芪、生薑放入鍋內,用大火燒開,去浮沫,改用文火煮至魚熟湯濃,食魚、飲湯。
功效:本方適用於慢性腎炎伴氣短、尿頻者。